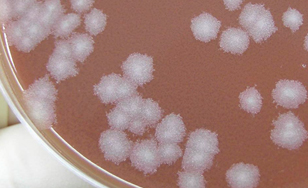

バイオテロや犯罪現場の環境試料、関係者の衣服・所持品及び生体成分等からの微生物の分離同定法、異同識別法の開発など鑑定に資する法微生物学研究をおこなう。
生物剤の解析及び検知・異同識別法の開発
バイオテロに用いられる可能性が高い細菌、ウイルス等の病原微生物及び細菌毒素(生物剤)を対象として、それらの簡易検知技術の開発、異同識別法の開発を行っている。

炭疽菌の芽胞及び莢膜発現増殖型
(ビクトリアブルー単染色)
炭疽菌のメデューサヘッド様コロニー
(血液寒天培地)

炭疽菌の増殖型
(透過型電子顕微鏡写真)